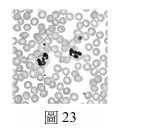

111學測自然
111學測自然科試題_55
含有Cr(VI)的化合物,如鉻酸根離子($CrO_4^{2-}$),簡稱六價鉻。生活用品的製程中常 產生六價鉻,成為影響水源的污染物。美國國家環境保護署(U.S. EPA)與世界衛生組 織(WHO),分別建議飲用水的鉻含量不可高於100 ppb與50 ppb($10^{-9}$ ,即十億分之 一)。如何有效移除水中六價鉻,一直是科學家試圖解決的課題。受到海綿的多孔結構 可以吸水的啟發,科學家以具有多孔結構的有機金屬骨架(簡稱MOF),吸附水中的六 價鉻。MOF材料除了能移除水中六價鉻外,亦可在酸性水溶液中,經照光將六價鉻轉變 成毒性較低的三價鉻(Cr(III))化合物,並將材料再生使用。
題組(55-57題)將相同重量的MOF材料,放入兩杯體積相同但六價鉻濃度不同的水溶液,靜置30分鐘後,測量水中六價鉻濃度,其結果顯示於圖24。下列敘述,哪些正確?(應選3項)
(A)MOF材料在溶液一與溶液二中,對六價鉻的移除率均高於70%
(B)MOF材料在溶液一與溶液二中,對六價鉻的移除率均低於30%
(C)處理過後的溶液一都同時符合EPA與WHO的飲用水標準
(D)處理過後的溶液二都同時符合EPA與WHO的飲用水標準
(E)本實驗的目的在測試MOF材料對於水溶液中六價鉻的吸附能力
111學測自然科試題_56
111學測自然科試題_57
111學測自然科試題_58
量子科學以光電科技改善了生活,也增進了質量國際標準的精密與穩定。科學家發現 電壓、電阻與電磁波能量等電磁量的量子單元,與普朗克常數$h$相關,因此訂$h=6.62607015\times10^{-34}J\cdot s$為新的質量基準。工程師使用類似於圖26的電磁天平來校準 質量,並利用經過量子單元校正的電磁量,來測量與換算線圈的電壓與電流,藉以連 結質量M與普朗克常數$h$。 某生利用積木製作一座類似於圖26等臂的電磁天平。圖中右側為秤盤,左側為線圈和磁 鐵,X與Y代表固定磁鐵的兩極。以支點為軸,線圈與秤盤可以是維持於水平的靜態模 式,或上下微幅振動的動態模式。
題組(58-60題)量子科學以光電科技改善了生活,也增進了質量國際標準的精密與穩定。科學家發現電壓、電阻與電磁波能量等電磁量的量子單元,與普朗克常數h相關,因此訂h=6.62607015×10^-34 J·s為新的質量基準。關於文中提到的物理量,哪個為基本量?
(A)質量 (B)電阻 (C)電壓 (D)能量 (E)磁場
111學測自然科試題_59
111學測自然科試題_60
題組(58-60題)靜態模式時,線圈電流$I$與磁鐵之間的作用力量值為$F_B=f_B I$。由於缺乏檢測$f_B$的設備,無法從靜態模式求得待測物的質量$M$。但可知,當線圈相對於磁鐵移動的速度為$v$時,線圈的感應電動勢(電壓)為$V=f_B v$,動態模式與靜態模式的$f_B$相同,示意如圖27。分析線圈速度$v$,以及對應的電壓表讀數$V$,其數據如表5,並繪製感應電壓對線圈速度($V-v$)的關係圖,如圖28所示,藉以推算$f_B$值。當天平達靜態平衡時,線圈電流為$I=40mA$,試以$kg$為單位,計算待測物的質量,須寫出計算步驟,並四捨五入至小數第1位。(已知重力加速度量值$g=9.8m/s^2$)